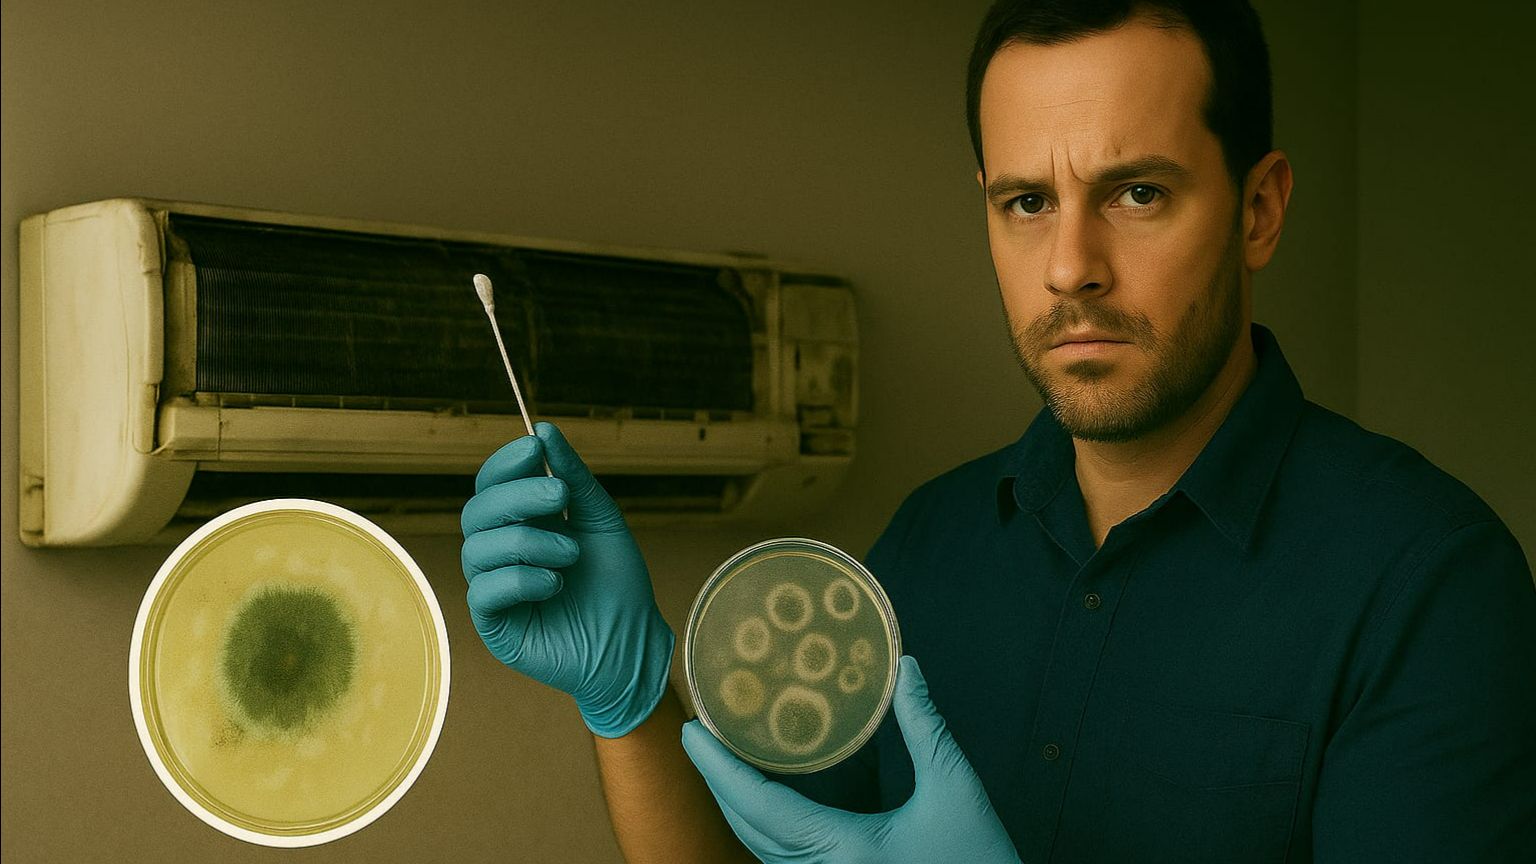
Плесень в Кондиционере: Взрыв Aspergillus за 24 Часа! Полный Эксперимент + Чистка СПб (60 мин) 😱 смотреть онлайн

Автор / Канал: freshairlife

Как почистить кондиционер самостоятельно

Включил кондиционер на тепло - сделай жалюзи подвижными - быстрее согреешь помещение!

Вакуумирование системы кондиционирования обязательно!

К чему приведет залом трассы кондиционера

Почему кондиционер пахнет канализацией!? как избавиться от запаха?

Сервис кондиционеров обязателен

Кондиционер в режиме обогрева, на улице -20°С

Правильный монтаж кондиционера с кратким расстоянием между блоками

Хочу мульти-сплит систему! А знаете ли Вы!

Как часто надо заправлять кондиционер! Точная информация в описании !

«Спрячь кондиционер, это некрасиво!»

❄️ КОНДИЦИОНЕР ДУЕТ ХОЛОДНЫМ ВОЗДУХОМ вместо тепла?

85 рублей. Ровно столько стоит ваша безопасность (и лобовое стекло соседа). 💸🚧

А Вы знаете где можно купить комфорт "под ключ" ?

Величайшая инженерная случайность XX века. Или почему вы платите не за холод. 📜❄️

Как "погибают" компрессора старого кондиционера зимой!

Эй! не замёрзли? У нас есть чем Вас согреть !

Хватит верить в «самоочистку» внутреннего блока. Это маркетинг для наивных. 🧼🚫

Монтаж кондиционера в Санкт-Петербурге

❄️ Кондиционер дует холодом вместо тепла? Или вообще перестал греть?

С Новым 2026 годом! Пожелание от Fresh Air Life 🎄

Почему вакуум НЕ СПАСЁТ от влаги? Трёхкратная сушка азотом опрессовка 30 бар Объект Санкт-Петербург

🔴 ДЛЯ КЛИЕНТОВ: Внутренняя инфа о плесени в кондиционерах! Шок для СПб (5 мин) УСЛУГА СЕРВИС КОНДЕЯ
Плесень в Кондиционере: Взрыв Aspergillus за 24 Часа! Полный Эксперимент + Чистка СПб (60 мин) 😱
За каждым успешным каналом стоит личность, идея и сотни часов кропотливого труда. Если вы здесь, значит, автор «freshairlife» уже сумел зацепить ваше внимание своим уникальным стилем или подачей. А мы на RUVIDEO позаботились о том, чтобы вы могли изучить весь архив его работ в максимально комфортных условиях — без лишней суеты и преград.
Почему за работами канала «freshairlife» так интересно наблюдать? Всё просто: это честный контент, который находит отклик в сердцах зрителей. На нашем ресурсе вы можете смотреть онлайн все видео любимого автора бесплатно и в хорошем качестве. Нам важно, чтобы вы видели каждую деталь и слышали каждый нюанс, поэтому мы используем только стабильные плееры из открытых источников Rutube.
Следите за новинками канала, пересматривайте старые шедевры и открывайте для себя новые грани творчества «freshairlife». Мы постоянно обновляем ленту, чтобы у вас под рукой всегда были самые свежие выпуски. Никаких сложных регистраций — только вы и творчество, которое вдохновляет. Приятного вам путешествия по миру авторского контента на RUVIDEO!
Видео взято из открытых источников Rutube. Если вы правообладатель, обратитесь к первоисточнику.